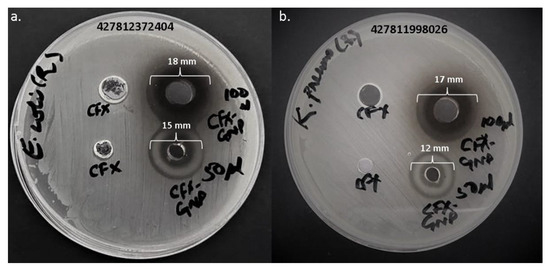

Abstract
Gold nanoparticles have gained popularity as an effective drug delivery vehicle due to their unique features. In fact, antibiotics transported via gold nanoparticles have significantly enhanced their potency in the recent past. The present study used an approach to synthesize gold nanoparticles in one step with the help of cefoxitin antibiotic as a reducing and stabilizing agent. Cefoxitin is a second-generation cephalosporin that loses its potential due to modification in the porins (ompK35 and ompK36) of Gram-negative pathogens. Thus, the present study has developed an idea to revive the potential of cefoxitin against clinical Gram-negative pathogens, i.e., Escherichia coli and Klebsiella pneumoniae, via applying gold nanoparticles as a delivery tool. Prior to antibacterial activity, characterization of cefoxitin–gold nanoparticles was performed via UV–visible spectrophotometry, dynamic light scattering, and electron microscopy. A characteristic UV–visible scan peak for gold nanoparticles was observed at 518 nm, ζ potential was estimated as −23.6 ± 1.6, and TEM estimated the size in the range of 2–12 nm. Moreover, cefoxitin loading efficiency on gold nanoparticles was calculated to be 71.92%. The antibacterial assay revealed that cefoxitin, after loading onto the gold nanoparticles, become potent against cefoxitin-resistant E. coli and K. pneumoniae, and their MIC50 values were estimated as 1.5 μg/mL and 2.5 μg/mL, respectively. Here, gold nanoparticles effectively deliver cefoxitin to the resistant pathogens, and convert it from unresponsive to a potent antibiotic. However, to obtain some convincing conclusions on the human relevance, their fate and toxicity need to be evaluated.
1. Introduction
Bacterial pathogens have developed different approaches to impede the effects of antibiotics in the past. Pathogenic strains have become capable of decreasing the permeability for antibiotics by modifying the outer membrane porins, developing pumps to efflux the antibiotics, and even directly destroying/modifying the antibiotics. Subsequently, the prevalence of antibiotic resistance has increased globally with time. Two of the most common Gram-negative sources of community or hospital-acquired infections, i.e., Escherichia coli and Klebsiella pneumoniae [1], have developed extended-spectrum beta-lactamase and modified outer-membrane porins in the recent past to escape the effect of the cephalosporin class of antibiotics [2,3,4,5,6,7]. The present study was focused on the resistance issues of E. coli and K. pneumoniae for cefoxitin, which is a second-generation cephalosporin. However, cefoxitin resistance in E. coli and K. pneumoniae has been associated with modification in non-specific outer membrane proteins ompK35 and ompK36 [6,7].
In the past, inorganic nanoparticles, specifically gold and silver nanoparticles, have allowed plausible solutions against resistance issues. They can form irreversible pores, disrupt the efflux pump, cause cell membrane disruption, and directly interact with bacterial biomolecules (nucleic acids, proteins, and lipids) [8,9,10,11]. In fact, several authors have used gold nanoparticles as a tool to deliver antibiotics to overcome resistance [12,13,14,15,16,17]. Gold nanoparticles are regarded as an optimal candidate for antibiotic delivery due to their biocompatibility and large ratio of surface area to volume. In addition, the attachment of the antibiotic to gold nanoparticles often tends to increase its potency by providing some additional bactericidal features. Increasing the cell wall porosity promotes the delivery of the attached antibiotic, and the direct interaction of gold nanoparticles with DNA could block the uncoiling and transcription processes. Interestingly, these features of gold nanoparticles will not only enhance the bactericidal activity but also assist in overcoming antibiotic resistance in some of the bacterial pathogens.
In 2017, cefotaxime resistance was successfully overcome by conjugating it on gold nanoparticles [17]. Similarly, ceftriaxone, ampicillin, and vancomycin resistance have been tackled efficaciously by applying gold nanoparticles as a delivery tool [15,18,19]. Thus, in the present study, gold nanoparticles loaded with cefoxitin were used to investigate their potential against cefoxitin-resistant pathogenic strains of E. coli and K. pneumoniae. Here, the cefoxitin-mediated synthesis of gold nanoparticles was performed, followed by characterization via dynamic light scattering, UV–visible spectroscopy, and electron microscopy. Further, the synthesized gold nanoparticles were tested against cefoxitin-resistant pathogenic strains of E. coli and K. pneumoniae. The implication of gold nanoparticles as a tool to deliver cefoxitin in resistant bacterial strains is one of the most feasible ways to tackle resistance issues. It is noteworthy to mention that authors have previously used a similar approach on third-generation cephalosporins successfully [14,15,17]. It is a universal fact that bacterial pathogens can find the means to become resistant with time to even newer classes of antibiotics by different mechanisms. In addition, scientists worldwide are expecting antibiotic resistance to become the next major issue after the COVID-19 pandemic. Thus, instead of spending time, intellectual efforts, and money on newer generations of antibiotics, if an older, ineffective antibiotic could be converted into a new and effective formulation, it will offer great relief for the scientific community.
2. Materials and Methods
2.1. Materials
Cefoxitin, solvents, media, and chemicals were purchased from Sigma Aldrich (St. Louis, MO, USA).
2.2. Synthesis of Gold Nanoparticles
Gold (III) chloride trihydrate salt solution (1 mM) in phosphate buffer (pH 7.2) was mixed with cefoxitin (250 μg) in a reaction mixture of 3 mL and incubated for 48 h at 40 °C [20]. After incubation, the reaction mixture color changed from yellow to ruby red, which confirmed the completion of the reaction and synthesis of gold nanoparticles. The synthesized cefoxitin-loaded gold nanoparticles were collected by centrifugating the mixture for 30 min at 30,000× g. Further, the nanoparticles were rinsed with 50% v/v ethanol and milli-Q water.
2.3. Characterization of Gold Nanoparticles
2.3.1. UV–Visible Spectroscopy
To assess the conversion of gold salt solution to gold nanoparticles, a double-beam spectrophotometer (UV-1601, Shimadzu, Tokyo, Japan) was used. The range from 200 to 800 nm at 1 nm resolution was used to conduct the scan.
2.3.2. Electron Microscopy
Transmission electron microscopy (TEM) for synthesized gold nanoparticles was performed on the Tecnai G2 Spirit TEM fitted with a BioTwin lens configuration (Hillsboro, OR, USA) after fixing the sample on a carbon-coated copper grid. The accelerating voltage of 80 kV was used to perform the analysis.
2.3.3. Dynamic Light Scattering (DLS)
The DLS approach was applied to estimate the hydrodynamic diameter and zeta potential of the synthesized nanoparticles by using the Malvern Zetasizer Nano-ZS (ZEN3600, Malvern Instrument Ltd., Malvern, UK). Prior to analysis, the synthesized gold nanoparticles were sonicated for 60 s and filtered by membrane filters (0.45 μm). The mean size of nanoparticles was estimated by taking a sample in a 1.5 mL disposable (DTS0112) cuvette. However, the particle surface charge (zeta potential) was measured by using DTS1070 disposable cuvettes [21].
2.4. Loading Efficiency Estimation
Cefoxitin loading efficacy on gold nanoparticles was estimated by using the methodology of Gomes et al. [22]. The reaction mixture of synthesized gold nanoparticles was centrifuged at 30,000× g for 30 min, and the supernatant was collected carefully. Free cefoxitin (unbounded cefoxitin) in the supernatant was calculated spectrophotometrically at 235 nm [23] by using the cefoxitin calibration curve pre-constructed at different concentrations. The following equation [22] was applied to calculate the loading efficacy percentage:
Loading efficacy (%) = [(X − Y)/X] × 100
X is the total amount of cefoxitin added during gold nanoparticle synthesis, whereas Y is the amount of free cefoxitin present in the supernatant.
2.5. Antibacterial Assay
2.5.1. Bacterial Strains
Escherichia coli (Seq# 427812372404) and Klebsiella pneumoniae (Seq# 427811998026) strains were collected from Hail General Hospital, Hail, to investigate the antibacterial activity of cefoxitin-loaded gold nanoparticles. Each bacterium was freshly inoculated in nutrient broth and incubated overnight at 37 °C. The turbidity was achieved to 0.5 McFarland standard (1.5 × 108 CFU/mL) with nutrient broth before evaluating the nanoparticles for antibacterial activity.
2.5.2. Agar Well Diffusion
The agar well diffusion technique [24] was applied to determine the efficacy of pure cefoxitin and cefoxitin-loaded gold nanoparticles. First, a 100 μL inoculum of each bacterial strain was swabbed twice on the surface of Mueller–Hinton agar plates to form a uniform lawn. Four holes (two 4 mm and two 8 mm diameter) were punched aseptically with a cork borer, and 50 μL (3 μg/well) and 100 μL (6 μg/well) of pure cefoxitin and cefoxitin-loaded gold nanoparticles were added to the wells. Petri plates were incubated at 37 °C overnight, and inspected for the zone of inhibition in mm. The experiment was repeated in triplicate, and the inhibition zone was measured as mean ± standard deviation.
2.5.3. Minimal Inhibitory Concentration (MIC)
The microbroth dilution method [25] was applied to calculate the MIC of cefoxitin-loaded gold nanoparticles against the tested strains of Escherichia coli and Klebsiella pneumoniae. The concentration range of 0.56 to 36 μg/mL for cefoxitin (loaded onto gold nanoparticles) was adjusted with sterile nutrient broth in a 96-well microtiter plate. The same concentration range was used for cefoxitin alone for comparative analysis. In each well, 10 μL of tested bacterial strain at 1.5 × 108 CFU/mL was inoculated. Plates were incubated overnight at 37 °C after inoculation, and an ELISA reader was used to measure the viability at 625 nm. The minimum concentration that inhibited the growth of the tested strains was recorded as the MIC, and phosphate buffer was used as a control. Three independent experiments were set up to obtain the MIC result as mean ± standard deviation.
3. Results and Discussion
3.1. Cefoxitin-Loaded Gold Nanoparticle Synthesis
There are multiple ways to synthesize gold nanoparticles of the desired size and property [26,27,28]. They include the use of chemical reducing agents such as sodium borohydrate, citrate, etc. However, post-synthesis, a stabilizing/capping agent is necessary to stabilize the synthesized gold nanoparticles [29,30]. Researchers have developed an idea to use natural reducing agents such as bromelain, trypsin, and herbal extracts, which could act as both reducing and capping agents to make the process easier, and this is termed the one-pot synthesis method [20,31,32]. However, the loading or attachment of drugs to the stabilized gold nanoparticles is a tedious task that includes the use of chemical cross-linking agents such as EDC (1-ethyl-3-(3-dimethylaminopropyl) carbodiimide) [17,33,34]. Thus, nano-scientists have developed protocols where the drug itself acts as a reducing as well as capping agent to minimize the use of chemicals. Similarly, in the present study, cefoxitin was used to mediate the synthesis of gold nanoparticles by acting as a reducing and capping agent (Figure 1). This strategy provided us with a method to synthesize stable nanoparticles and achieve subsequent cefoxitin attachment in one step. Earlier reports on β-lactam antibiotics suggested that their amine group participates in the reduction of gold and silver salts, and no changes in the β-lactam ring were observed even after the capping/stabilization of nanoparticles [16,35]. In fact, one-pot synthesis via antibiotics (without the use of chemical reducing/stabilizing/cross-linking agents) will minimize the probability of any false antibacterial results because of residual chemicals used in the processing of nanoparticles. Several authors have applied an antibiotic-mediated gold nanoparticle synthesis strategy in the recent past [12,14,15,16]. Interestingly, they have found enhanced potential against pathogenic bacterial strains.

Figure 1.
Scheme for the synthesis and stabilization of gold nanoparticles by cefoxitin.
In the current study, cefoxitin (250 μg) was added to a 3 mL reaction mixture containing 1 mM of gold salt in phosphate buffer (pH 7.2). It has been observed that the pH influences the zeta potential of the gold nanoparticle monolayer [36]. However, the pH of 7.2 for the present study was selected on the basis of an earlier reported method [20]. Further, the reaction mixture was kept at 40 °C for two days to complete the formation of gold nanoparticles after successful reduction and capping. Time-to-time physical observation and UV–vis scanning were performed to check the success of the synthesis protocol. The color of the reaction mixture changed from yellow to the characteristic ruby red color, which confirmed the formation of gold nanoparticles. The sample was further characterized by UV–vis scanning, zeta sizing and potential measurement, and electron microscopy.
3.2. Characterization of Cefoxitin-Loaded Gold Nanoparticles
Gold nanoparticles show characteristic surface plasma resonance (SPR) in the visible range of 500 to 600 nm. In the current study, the SPR band peak for the synthesized gold nanoparticles was observed at 518 nm (Figure 2). In addition, a peak at 235 nm was also observed that corresponded to the cefoxitin loaded onto gold nanoparticles [23]. However, the color change from yellow to ruby red, shown in Figure 2 (inset), also corresponds to the successful synthesis of gold nanoparticles. Thus, cefoxitin successfully mediated the synthesis of stable gold nanoparticles. A similar approach was used for the synthesis of cefotaxime, ceftriaxone, delafloxacin, and vancomycin–gold nanoparticles in the recent past [12,14,15]. Interestingly, dual peaks were observed for cefotaxime (260 nm), ceftriaxone (241 nm), delafloxacin (290 nm), and vancomycin (278 nm), and their synthesized gold nanoparticles, at 532 nm, 536 nm, 530 nm, and 524 nm, respectively [12,14,15]. In fact, if the antibiotics were attached to the gold nanoparticles by using EDC, two peaks—one for the antibiotic and one for the gold nanoparticles—were reported [17,34]. Hence, it can be safely stated that cefoxitin was successfully loaded onto gold nanoparticles after synthesis in the current study.

Figure 2.
UV–vis spectroscopy scan of the cefoxitin-synthesized gold nanoparticles. (Inset) Physical observation of the change in color from yellow to ruby red.
To determine the size distribution of the cefoxitin-synthesized gold nanoparticles in the dispersion, the dynamic light scattering (DLS) technique was used. In fact, during DLS analysis, the arbitrary variations in the light intensity scattered by the dispersion of nanoparticles are used to estimate the size [37]. The Z-average mean size was estimated as 51 nm for the cefoxitin-synthesized gold nanoparticles in the present study (Figure 3). On the other hand, zeta potential was used to assess the surface charge on gold nanoparticles, which showed their colloidal dispersion stability [38]. It was actually dependent on the level of electrostatic repulsion within the similarly charged particles in the dispersion. In the current study, the zeta potential value of cefoxitin-synthesized gold nanoparticles was calculated as −23.6 mV (Figure 3 inset). It has been reported that particles with higher +ve or −ve zeta potential (>±20 mV) repel each other, and will not be aggregated easily [39]. Hence, the cefoxitin-synthesized gold nanoparticles of the present study were found to be stable. However, the high negative charge might be attributed to the presence of functional groups in the cefoxitin antibiotic loaded on the surfaces of the gold nanoparticles.

Figure 3.
Size distribution intensity plot generated by dynamic light scattering for cefoxitin-synthesized gold nanoparticles. (Inset) Zeta potential of the synthesized gold nanoparticles.
Transmission electron microscopy (TEM) was used to depict the size of the inorganic core of the cefoxitin–gold nanoparticles. Two different magnifications were used for TEM imaging: 30,000× (Figure 4a) and 1,000,000× (Figure 4b). TEM images for cefoxitin–gold nanoparticles revealed that the cefoxitin–gold nanoparticles were poly-dispersed, with a size of 2–12 nm. No aggregation was observed in the TEM images, which corresponds to effective capping/stabilization via cefoxitin. Size differences in the cefoxitin–gold nanoparticles evaluated by DLS (51 nm) and TEM (2–12 nm) could be observed in this study that might be due to the different principles of size calculation. TEM sizing is based on transmission electrons and provides information of the inorganic core, whereas DLS estimates the size of nanoparticles in a hydration state, which includes the information of the solvent layer adhered to them in the liquid medium [40,41,42,43,44]. Thus, the size estimation by DLS is relatively higher than that by TEM. This aspect of the size measurement of gold nanoparticles has been reported in several previous investigations as well [12,13,14,15].

Figure 4.
TEM images of cefoxitin–gold nanoparticles (a) at 30,000× and (b) at 1,000,000×.
3.3. Loading Efficacy
One crucial parameter for the characterization of nanoparticles and their subsequent application is the calculation of the loading efficiency of the drug onto nanoparticles. In this study, cefoxitin’s loading efficiency onto gold nanoparticles was estimated as 71.92%. Here, 250 μg of cefoxitin was initially added to the reaction mixture; however, 179.8 μg (approx. 180 μg) was estimated to be loaded onto the gold nanoparticles. This indicates no substantial loss of cefoxitin during the processing conditions, and the efficacious loading of cefoxitin on the surfaces of the gold nanoparticles.
3.4. Antibacterial Assay
The antibacterial activity of cefoxitin–gold nanoparticles and pure cefoxitin was estimated against clinical strains of Escherichia coli and Klebsiella pneumoniae. The well diffusion technique was applied to preliminarily screen the potential of pure cefoxitin and cefoxitin–gold nanoparticles (Table 1, Figure 5). At a 3 μg/well concentration, cefoxitin–gold nanoparticles showed 12 mm and 15 mm zones of inhibition against K. pneumoniae and E. coli, respectively. At a 6 μg/well concentration, the zone of inhibition increased to 17 mm and 18 mm against K. pneumoniae and E. coli, respectively. However, at both the concentrations, 3 and 6 μg/well, pure cefoxitin showed no antibacterial activity against the tested strains. Thus, it can be suggested that the gold nanoparticles significantly revived cefoxitin’s potential against the tested bacterial strains.

Table 1.
Antibacterial activity assessment by well diffusion method.
Figure 5.
Antibacterial activity of cefoxitin (CFX) and cefoxitin–gold nanoparticles (CFX-GNP) against (a) Escherichia coli and (b) Klebsiella pneumoniae.
It is noteworthy to mention that cefoxitin (a second-generation cephalosporin) was once considered as an alternative if the bacterial strain developed resistance towards other second-generation cephalosporins, due to its resistance towards β-lactamase/cephalosporinase [45]. However, past reports suggested that bacterial strains have gained resistance towards cefoxitin as well by alternate mechanisms [6,7,46,47,48]. It has been reported that cefoxitin resistance in K. pneumoniae and E. coli is linked with porins or non-specific outer-membrane proteins ompK35 and ompK36 [6,7]. In fact, porins are water-filled channels that allow the diffusion of the β-lactam antibiotic via the outer membrane. However, cefoxitin (β-lactam antibiotic) resistance is due to the loss or modification of these porin channels [6]. Gold nanoparticles have the capability to form pores in the outer membranes of Gram-negative bacterial strains and cause cell membrane disruption [8,9,10]. Hence, they can deliver the antibiotic attached to them in a more efficient manner, even though the porins are lost or modified. The current study showed that cefoxitin resistance was overcome after loading onto gold nanoparticles. These results are supported by other studies conducted on third-generation cephalosporins (cefotaxime and ceftriaxone) in the recent past [14,15]. They used different Gram-positive and Gram-negative strains of non-clinical origin to test the antibacterial efficacy [14,15]. However, the current study used a second-generation cephalosporin against the clinical uro-pathogenic resistant strains of K. pneumoniae and E. coli. An additional benefit of gold nanoparticles as an antibiotic carrier is that they offer a large surface area to deliver a good amount of antibiotic to the bacterial cell. Therefore, it is anticipated that the gold nanoparticles might have delivered a larger cefoxitin quantity to the tested strains in comparison to cefoxitin alone. The gold nanoparticle itself is capable of interacting with the biomolecules of bacterial cells, and causes substantial damage to the cell. Thus, cefoxitin’s successful delivery might have provided a synergistic attack on the bacterial cell. Further, the minimum inhibitory concentration (MIC50) was calculated for cefoxitin–gold nanoparticles against K. pneumoniae and E. coli. The MIC50 for cefoxitin–gold nanoparticles was estimated as 1.5 μg/mL against E. coli and 2.5 μg/mL against K. pneumoniae (Figure 6). On the other hand, cefoxitin alone showed an MIC50 of 19.5 μg/mL and 23 μg/mL against E. coli and K. pneumoniae, respectively. All these results evidently prove that nanotechnology could augment the potency of cefoxitin via loading onto gold nanoparticles. Importantly, an easy one-pot synthesis approach was applied in the present study (without the use of any external chemical reducing/capping agent) to produce effective cefoxitin–gold nanoparticles. Conclusively, it can be proposed that gold nanoparticles, as a cefoxitin carrier, might be applied in the future to overcome/reduce the probability of cefoxitin resistance.

Figure 6.
MIC50 of cefoxitin–gold nanoparticles and pure cefoxitin against Escherichia coli and Klebsiella pneumoniae.
4. Conclusions
The conversion of an ineffective antibiotic into a potent antibiotic nano-formulation is an appealing idea in the current scenario of increasing resistance towards different classes of antibiotics. The present study used a one-pot gold nanoparticle synthesis approach to revive cefoxitin’s potential against resistant clinical pathogens. Here, cefoxitin acted as a reducing and capping agent to produce gold nanoparticles of high stability (ζ potential −23.6 ± 1.6), with 180 μg of cefoxitin (loading efficacy of 71.92%) loaded onto them. The antibacterial assay clearly indicated that cefoxitin, after loading onto gold nanoparticles, became significantly more potent against the tested clinical strains of Escherichia coli and Klebsiella pneumoniae. Meanwhile, at the same concentration, pure cefoxitin showed no activity against both strains. The results of the present study suggested that loading an antibiotic (cefoxitin) onto gold nanoparticles could provide a good strategy to resolve the resistance-related issues. However, in vivo studies are warranted to investigate the toxicity and fate of cefoxitin–gold nanoparticles before considering their applicability.
Author Contributions
Conceptualization, A.A., S.M.D.R. and A.B.F.A.; methodology, S.M.D.R., A.S.A. and S.S.M.F.; software, A.S.A.L. and A.A.K.; validation, A.S.A.L., A.A.K. and E.-S.K.; formal analysis, A.S.A.L.; resources, A.A., A.S.A., S.S.M.F. and H.F.A.; writing—original draft preparation, S.M.D.R., A.S.A. and A.A.K.; writing—review and editing, A.A., E.-S.K. and H.F.A.; visualization, A.B.F.A.; supervision, A.A., S.M.D.R. and A.B.F.A.; project administration, E.-S.K. and H.F.A.; funding acquisition, E.-S.K. and H.F.A. All authors have read and agreed to the published version of the manuscript.
Funding
This work was supported by the Princess Nourah bint Abdulrahman University Researcher Supporting Project (number PNURSP2022R205), Princess Nourah bint Abdulrahman University, Riyadh, Saudi Arabia.
Institutional Review Board Statement
Not applicable.
Informed Consent Statement
Not applicable.
Data Availability Statement
Not applicable.
Acknowledgments
The authors extend their appreciation to Princess Nourah bint Abdulrahman University, Riyadh, Saudi Arabia for supporting this work under the Researcher Supporting Project (number PNURSP2022R205).
Conflicts of Interest
The authors declare no conflict of interest.
References
- Costa, F.S.L.; Bezerra, C.C.R.; Neto, R.M.; Morais, C.L.M.; Lima, K.M.G. Identification of resistance in Escherichia coli and Klebsiella pneumoniae using excitation-emission matrix fluorescence spectroscopy and multivariate analysis. Sci. Rep. 2020, 10, 12994. [Google Scholar] [CrossRef] [PubMed]
- Tsai, Y.K.; Fung, C.P.; Lin, J.C.; Chen, J.H.; Chang, F.Y.; Chen, T.L.; Siu, L.K. Klebsiella pneumoniae outer membrane porins OmpK35 and OmpK36 play roles in both antimicrobial resistance and virulence. Antimicrob. Agents Chemother. 2011, 55, 1485–1493. [Google Scholar] [CrossRef] [PubMed]
- Hernández-Allés, S.; Conejo, M.; Pascual, A.; Tomás, J.M.; Benedí, V.J.; Martínez-Martínez, L. Relationship between outer membrane alterations and susceptibility to antimicrobial agents in isogenic strains of Klebsiella pneumoniae. J. Antimicrob. Chemother. 2000, 46, 273–277. [Google Scholar] [CrossRef] [PubMed]
- Shaikh, S.; Rizvi, S.M.; Anis, R.; Shakil, S. Prevalence of CTX-M resistance marker and integrons among Escherichia coli and Klebsiella pneumoniae isolates of clinical origin. Lett. Appl. Microbiol. 2016, 62, 419–427. [Google Scholar] [CrossRef][Green Version]
- Shaikh, S.; Fatima, J.; Shakil, S.; Rizvi, S.M.; Kamal, M.A. Risk factors for acquisition of extended spectrum beta lactamase producing Escherichia coli and Klebsiella pneumoniae in North-Indian hospitals. Saudi J. Biol. Sci. 2015, 22, 37–41. [Google Scholar] [CrossRef] [PubMed]
- Ananthan, S.; Subha, A. Cefoxitin resistance mediated by loss of a porin in clinical strains of Klebsiella pneumoniae and Escherichia coli. Indian J. Med. Microbiol. 2005, 23, 20–23. [Google Scholar] [CrossRef]
- Shi, W.; Li, K.; Ji, Y.; Jiang, Q.; Wang, Y.; Shi, M.; Mi, Z. Carbapenem and cefoxitin resistance of Klebsiella pneumoniae strains associated with porin OmpK36 loss and DHA-1 β-lactamase production. Braz. J. Microbiol. 2013, 44, 435–442. [Google Scholar] [CrossRef]
- Okkeh, M.; Bloise, N.; Restivo, E.; De Vita, L.; Pallavicini, P.; Visai, L. Gold Nanoparticles: Can They Be the Next Magic Bullet for Multidrug-Resistant Bacteria? Nanomaterials 2021, 11, 312. [Google Scholar] [CrossRef]
- Białas, N.; Sokolova, V.; van der Meer, S.B.; Knuschke, T.; Ruks, T.; Klein, K.; Westendorf, A.M.; Epple, M. Bacteria (E. coli) take up ultrasmall gold nanoparticles (2 nm) as shown by different optical microscopic techniques (CLSM, SIM, STORM). Nano Sel. 2022, 3, 1407–1420. [Google Scholar] [CrossRef]
- Joshi, A.S.; Singh, P.; Mijakovic, I. Interactions of Gold and Silver Nanoparticles with Bacterial Biofilms: Molecular Interactions behind Inhibition and Resistance. Int. J. Mol. Sci. 2020, 21, 7658. [Google Scholar] [CrossRef]
- Shaikh, S.; Nazam, N.; Rizvi, S.M.D.; Ahmad, K.; Baig, M.H.; Lee, E.J.; Choi, I. Mechanistic Insights into the Antimicrobial Actions of Metallic Nanoparticles and Their Implications for Multidrug Resistance. Int. J. Mol. Sci. 2019, 20, 2468. [Google Scholar] [CrossRef] [PubMed]
- Abu Lila, A.S.; Huwaimel, B.; Alobaida, A.; Hussain, T.; Rafi, Z.; Mehmood, K.; Abdallah, M.H.; Hagbani, T.A.; Rizvi, S.M.D.; Moin, A.; et al. Delafloxacin-Capped Gold Nanoparticles (DFX-AuNPs): An Effective Antibacterial Nano-Formulation of Fluoroquinolone Antibiotic. Materials 2022, 15, 5709. [Google Scholar] [CrossRef] [PubMed]
- Hagbani, T.A.; Yadav, H.; Moin, A.; Lila, A.S.A.; Mehmood, K.; Alshammari, F.; Khan, S.; Khafagy, E.S.; Hussain, T.; Rizvi, S.M.D.; et al. Enhancement of Vancomycin Potential against Pathogenic Bacterial Strains via Gold Nano-Formulations: A Nano-Antibiotic Approach. Materials 2022, 15, 1108. [Google Scholar] [CrossRef] [PubMed]
- Al Hagbani, T.; Rizvi, S.M.D.; Hussain, T.; Mehmood, K.; Rafi, Z.; Moin, A.; Abu Lila, A.S.; Alshammari, F.; Khafagy, E.S.; Rahamathulla, M.; et al. Cefotaxime Mediated Synthesis of Gold Nanoparticles: Characterization and Antibacterial Activity. Polymers 2022, 14, 771. [Google Scholar] [CrossRef]
- Alshammari, F.; Alshammari, B.; Moin, A.; Alamri, A.; Al Hagbani, T.; Alobaida, A.; Baker, A.; Khan, S.; Rizvi, S.M.D. Ceftriaxone Mediated Synthesized Gold Nanoparticles: A Nano-Therapeutic Tool to Target Bacterial Resistance. Pharmaceutics 2021, 13, 1896. [Google Scholar] [CrossRef]
- Rai, A.; Prabhune, A.; Perry, C.C. Antibiotic mediated synthesis of gold nanoparticles with potent antimicrobial activity and their application in antimicrobial coatings. J. Mater. Chem. 2010, 20, 6789–6798. [Google Scholar] [CrossRef]
- Shaikh, S.; Rizvi, S.M.D.; Shakil, S.; Hussain, T.; Alshammari, T.M.; Ahmad, W.; Tabrez, S.; Al-Qahtani, M.H.; Abuzenadah, A.M. Synthesis and Characterization of Cefotaxime Conjugated Gold Nanoparticles and Their Use to Target Drug-Resistant CTX-M-Producing Bacterial Pathogens. J. Cell Biochem. 2017, 118, 2802–2808. [Google Scholar] [CrossRef]
- Wang, S.G.; Chen, Y.C. Antibacterial gold nanoparticle-based photothermal killing of vancomycin-resistant bacteria. Nanomedicine 2018, 13, 1405–1416. [Google Scholar] [CrossRef]
- Chavan, C.; Kamble, S.; Murthy, A.V.R.; Kale, S.N. Ampicillin-mediated functionalized gold nanoparticles against ampicillin-resistant bacteria: Strategy, preparation and interaction studies. Nanotechnology 2020, 31, 215604. [Google Scholar] [CrossRef]
- Khan, S.; Danish Rizvi, S.M.; Avaish, M.; Arshad, M.; Bagga, P.; Khan, M.S. A novel process for size controlled biosynthesis of gold nanoparticles using bromelain. Mater. Lett. 2015, 159, 373–376. [Google Scholar] [CrossRef]
- Soliman, W.E.; Khan, S.; Rizvi, S.M.D.; Moin, A.; Elsewedy, H.S.; Abulila, A.S.; Shehata, T.M. Therapeutic Applications of Biostable Silver Nanoparticles Synthesized Using Peel Extract of Benincasa hispida: Antibacterial and Anticancer Activities. Nanomaterials 2020, 10, 1954. [Google Scholar] [CrossRef] [PubMed]
- Gomes, M.J.; Martins, S.; Ferreira, D.; Segundo, M.A.; Reis, S. Lipid nanoparticles for topical and transdermal application for alopecia treatment: Development, physicochemical characterization, and in vitro release and penetration studies. Int. J. Nanomed. 2014, 9, 1231–1242. [Google Scholar] [CrossRef]
- Attia, K.A.-S.M.; Abdel-Aziz, O.; Magdy, N.; Mohamed, G.F. Development and validation of different chemometric-assisted spectrophotometric methods for determination of cefoxitin-sodium in presence of its alkali-induced degradation product. Future J. Pharm. Sci. 2018, 4, 241–247. [Google Scholar] [CrossRef]
- Balouiri, M.; Sadiki, M.; Ibnsouda, S.K. Methods for in vitro evaluating antimicrobial activity: A review. J. Pharm. Anal. 2016, 6, 71–79. [Google Scholar] [CrossRef]
- Akinyemi, K.O.; Oladapo, O.; Okwara, C.E.; Ibe, C.C.; Fasure, K.A. Screening of crude extracts of six medicinal plants used in South-West Nigerian unorthodox medicine for anti-methicillin resistant Staphylococcus aureus activity. BMC Complement. Altern. Med. 2005, 5, 6. [Google Scholar] [CrossRef]
- Suchomel, P.; Kvitek, L.; Prucek, R.; Panacek, A.; Halder, A.; Vajda, S.; Zboril, R. Simple size-controlled synthesis of Au nanoparticles and their size-dependent catalytic activity. Sci. Rep. 2018, 8, 4589. [Google Scholar] [CrossRef]
- Piella, J.; Bastús, N.G.; Puntes, V. Size-Controlled Synthesis of Sub-10-nanometer Citrate-Stabilized Gold Nanoparticles and Related Optical Properties. Chem. Mater. 2016, 28, 1066–1075. [Google Scholar] [CrossRef]
- Amina, S.J.; Guo, B. A Review on the Synthesis and Functionalization of Gold Nanoparticles as a Drug Delivery Vehicle. Int. J. Nanomed. 2020, 15, 9823–9857. [Google Scholar] [CrossRef]
- Kang, H.; Buchman, J.T.; Rodriguez, R.S.; Ring, H.L.; He, J.; Bantz, K.C.; Haynes, C.L. Stabilization of Silver and Gold Nanoparticles: Preservation and Improvement of Plasmonic Functionalities. Chem. Rev. 2019, 119, 664–699. [Google Scholar] [CrossRef]
- Ibrahim, A.M.; Alzahrani, H.A.A.; Abd El-Latif, M.M.; Selim, M.M. Influence of different stabilizers on the morphology of gold nanoparticles. Bull. Natl. Res. Cent. 2019, 43, 33. [Google Scholar] [CrossRef]
- Elia, P.; Zach, R.; Hazan, S.; Kolusheva, S.; Porat, Z.; Zeiri, Y. Green synthesis of gold nanoparticles using plant extracts as reducing agents. Int. J. Nanomed. 2014, 9, 4007–4021. [Google Scholar] [CrossRef]
- Muddapur, U.M.; Alshehri, S.; Ghoneim, M.M.; Mahnashi, M.H.; Alshahrani, M.A.; Khan, A.A.; Iqubal, S.M.S.; Bahafi, A.; More, S.S.; Shaikh, I.A.; et al. Plant-Based Synthesis of Gold Nanoparticles and Theranostic Applications: A Review. Molecules 2022, 27, 1391. [Google Scholar] [CrossRef] [PubMed]
- Iram, S.; Zahera, M.; Wahid, I.; Baker, A.; Raish, M.; Khan, A.; Ali, N.; Ahmad, S.; Khan, M.S. Cisplatin bioconjugated enzymatic GNPs amplify the effect of cisplatin with acquiescence. Sci. Rep. 2019, 9, 13826. [Google Scholar] [CrossRef] [PubMed]
- Khan, S.; Haseeb, M.; Baig, M.H.; Bagga, P.S.; Siddiqui, H.H.; Kamal, M.A.; Khan, M.S. Improved efficiency and stability of secnidazole—An ideal delivery system. Saudi J. Biol. Sci. 2015, 22, 42–49. [Google Scholar] [CrossRef] [PubMed]
- Khatoon, N.; Alam, H.; Khan, A.; Raza, K.; Sardar, M. Ampicillin silver nanoformulations against multidrug resistant bacteria. Sci. Rep. 2019, 9, 6848. [Google Scholar] [CrossRef]
- Maciejewska-Prończuk, J.; Morga, M.; Adamczyk, Z.; Oćwieja, M.; Zimowska, M. Homogeneous gold nanoparticle monolayers—QCM and electrokinetic characteristics. Colloids Surf. A Physicochem. Eng. Asp. 2017, 514, 226–235. [Google Scholar] [CrossRef]
- Kato, H.; Nakamura, A.; Takahashi, K.; Kinugasa, S. Accurate Size and Size-Distribution Determination of Polystyrene Latex Nanoparticles in Aqueous Medium Using Dynamic Light Scattering and Asymmetrical Flow Field Flow Fractionation with Multi-Angle Light Scattering. Nanomaterials 2012, 2, 15–30. [Google Scholar] [CrossRef]
- Rasmussen, M.K.; Pedersen, J.N.; Marie, R. Size and surface charge characterization of nanoparticles with a salt gradient. Nat. Commun. 2020, 11, 2337. [Google Scholar] [CrossRef]
- Xu, R. Progress in nanoparticles characterization: Sizing and zeta potential measurement. Particuology 2008, 6, 112–115. [Google Scholar] [CrossRef]
- Al Saqr, A.; Khafagy, E.S.; Alalaiwe, A.; Aldawsari, M.F.; Alshahrani, S.M.; Anwer, M.K.; Khan, S.; Lila, A.S.A.; Arab, H.H.; Hegazy, W.A.H. Synthesis of Gold Nanoparticles by Using Green Machinery: Characterization and In Vitro Toxicity. Nanomaterials 2021, 11, 808. [Google Scholar] [CrossRef]
- Souza, T.G.; Ciminelli, V.S.; Mohallem, N.D. A comparison of TEM and DLS methods to characterize size distribution of ceramic nanoparticles. J. Phys. Conf. Ser. 2016, 733, 012039. [Google Scholar] [CrossRef]
- Hackley, V.A.; Clogston, J.D. Measuring the hydrodynamic size of nanoparticles in aqueous media using batch-mode dynamic light scattering. In Characterization of Nanoparticles Intended for Drug Delivery; Humana Press: Totova, NJ, USA, 2011; pp. 35–52. [Google Scholar]
- Zheng, T.; Bott, S.; Huo, Q. Techniques for accurate sizing of gold nanoparticles using dynamic light scattering with particular application to chemical and biological sensing based on aggregate formation. ACS Appl. Mater. Interfaces 2016, 8, 21585–21594. [Google Scholar] [CrossRef] [PubMed]
- Wilson, B.K.; Prud’homme, R.K. Nanoparticle size distribution quantification from transmission electron microscopy (TEM) of ruthenium tetroxide stained polymeric nanoparticles. J. Colloid Interface Sci. 2021, 604, 208–220. [Google Scholar] [CrossRef] [PubMed]
- Darland, G.; Birnbaum, J. Cefoxitin resistance to beta-lactamase: A major factor for susceptibility of Bacteroides fragilis to the antibiotic. Antimicrob. Agents Chemother. 1977, 11, 725–734. [Google Scholar] [CrossRef]
- Avkan-Oğuz, V.; Baykam, N.; Korten, V.; Abdullayeva, M.; Yapar, D.; Mülazımoğlu, L.; Gülay, Z. Antimicrobial Resistance and Molecular Patterns in Community-acquired Complicated Intra-abdominal Infections: A Multicentric Study. Infect. Dis. Clin. Microbiol. 2020, 2, 71–78. [Google Scholar] [CrossRef]
- Fernandes, C.J.; Fernandes, L.A.; Collignon, P. Cefoxitin resistance as a surrogate marker for the detection of methicillin-resistant Staphylococcus aureus. J. Antimicrob. Chemother. 2005, 55, 506–510. [Google Scholar] [CrossRef]
- Gharout-Sait, A.; Touati, A.; Guillard, T.; Brasme, L.; Champs, C.D. Molecular characterization and epidemiology of cefoxitin resistance among Enterobacteriaceae lacking inducible chromosomal ampC genes from hospitalized and non-hospitalized patients in Algeria: Description of new sequence type in Klebsiella pneumoniae isolates. Braz. J. Infect. Dis. 2015, 19, 187–195. [Google Scholar]
Publisher’s Note: MDPI stays neutral with regard to jurisdictional claims in published maps and institutional affiliations. |
© 2022 by the authors. Licensee MDPI, Basel, Switzerland. This article is an open access article distributed under the terms and conditions of the Creative Commons Attribution (CC BY) license (https://creativecommons.org/licenses/by/4.0/).